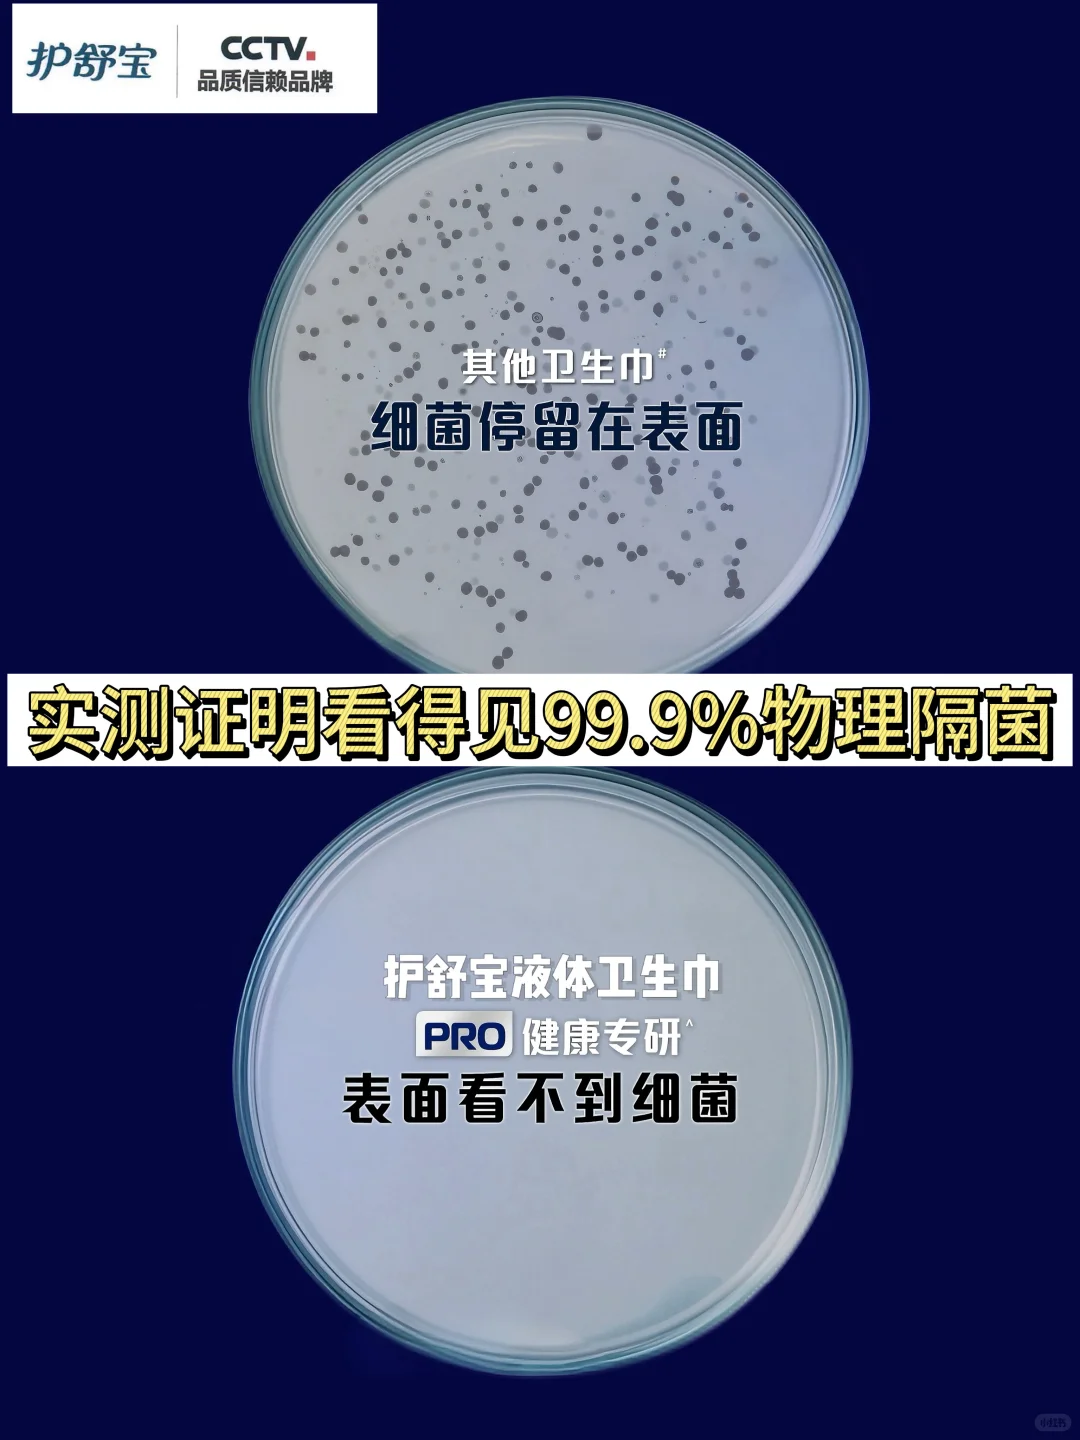

·
今日菜单📝
羊肚菌浓汤🍄🟫
白灼虾🦐
白灼芦笋🍃
肉酱滑蛋饭🍳
黄油桃🍑
红糖小圆子🧆
姜枣茶🫚
每个月的那几天都像一场特殊的小战役💪🏻
今天做了姨妈期小套餐给自己补补身子
梅花肉浓汤 里面有很多蔬菜 好喝~
这个汤我一年也就做个125次吧🧏🏻♀️
今天还放了一些羊肚菌 姨妈期养养胃
我朋友常说肉宝你每天电量好足啊!
我说:那是 我姨妈可以到55岁哈哈哈
经期饮食我也有自己得一套心得~
多吃含铁的食物 比如:红肉、动物内脏🥩
含维C的食物:温性的一些水果和彩椒🫑
高蛋白的食物:三文鱼、虾和牛奶🥛
含镁的食物:坚果、牛油果🥑
还需要优质脂肪:黑芝麻和橄榄油等~
好好吃饭 好好睡觉 多喝热水!🫶🏻
姨妈期好好爱自己对我们女生来说太重要了
除了食物上的能量补给 贴身用的卫生巾
也要好好挑选内补外护缺一不可!
之前总以为是自己护理不到位
其实都是卫生巾没选对😮💨
闷痒异味啥的都是经血湿湿的闷久了
滋生细菌刺激皮肤导致的
这款新出的护舒宝卫生巾PRO健康专研 就是专门针对我们女生常有的经期闷痒的不适问题研发
我已经帮你们用过了 真的好好用啊!
它是0化学添加 独有的单向导湿表层
好比一个物理隔菌盾 隔菌率高达99.9%!
经血吸进去就沉底下出不来了
接触不到皮肤细菌自然不会滋生
物理隔菌的黑科技是真的绝绝子!
从根源解决了闷!湿!痒!
就算去瑜伽、骑车、蹦迪~
也是不闷不黏腻 清爽自在🫧
而且它是照着婴儿标准做的卫生巾
非常的亲肤 更安全更放心~
不愧是央视品质信赖的好品牌👍🏻
让每个月的那几天都能轻松度过 活力满满🧘🏻♀️
女生们食补都吃起来 护舒宝PRO用起来!
好好吃饭 好好呵护自己~